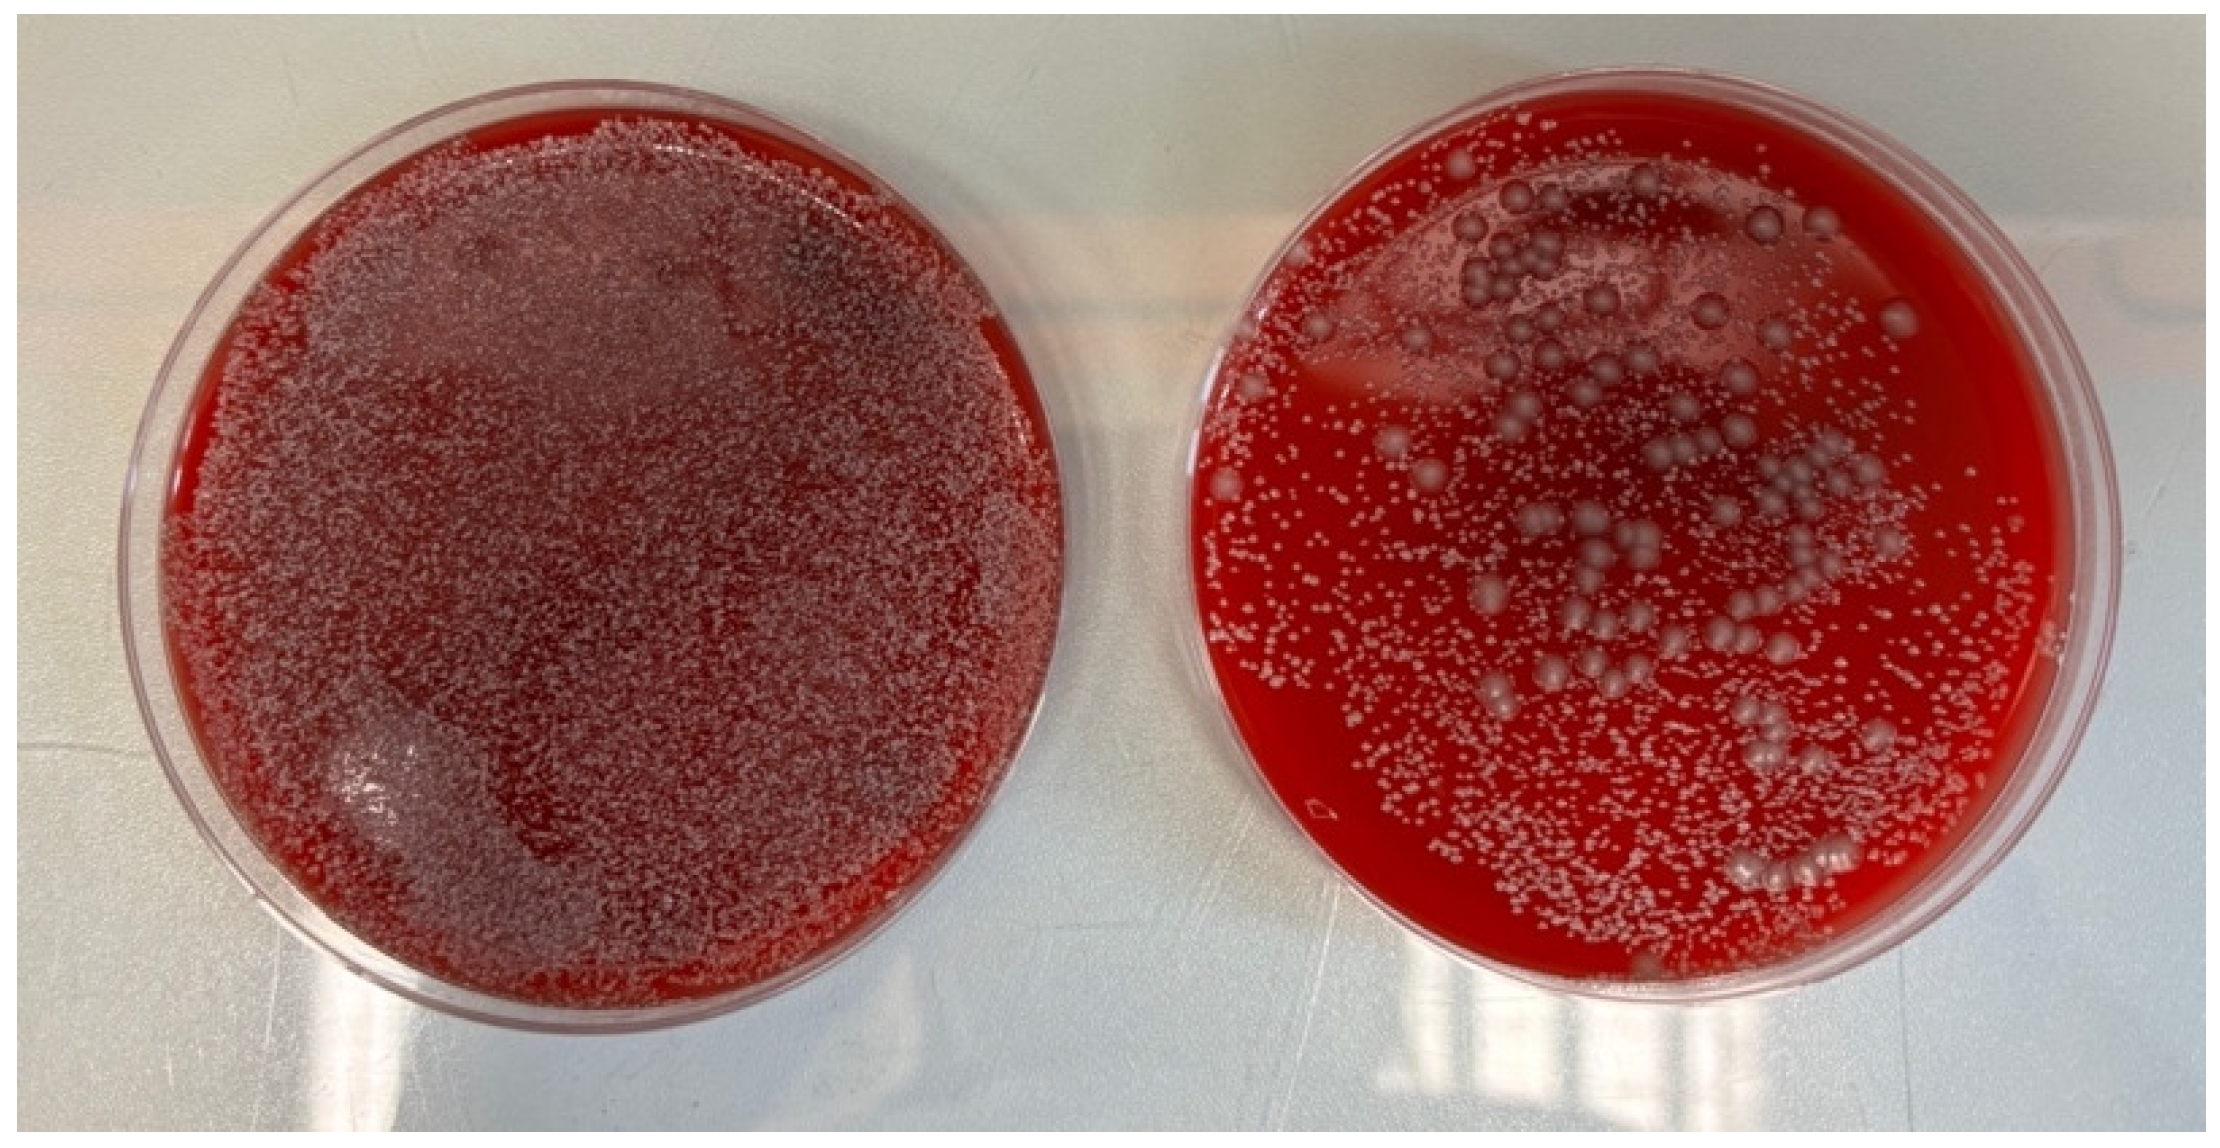

Reusable Tourniquets as Potential Transmitters of Infection: A Microbiological Analysis
Abstract
1. Introduction
2. Material and Methods
2.1. Study Design
2.2. Settings
2.3. Samples
2.4. Characteristics of Sampling Locations
2.5. Collection of Material
2.6. Enumeration of Microorganisms on Tourniquet Components
2.6.1. Plastic Claps
Study on Columbia Agar (Total Microbial Count)
2.6.2. Fabric Band
Study on Columbia Agar (Total Microbial Count)
Study on MacConkey Agar and King B Agar Plates (Gram-Negative Bacteria and Pseudomonas Count)
2.7. Statistical Methods
3. Results
3.1. Microbial Contamination
3.1.1. Abundance on Columbia Agar
3.1.2. Abundance on Qualitative Media
3.2. Blood Stains
4. Discussion
4.1. Key Results
4.1.1. Significance of Findings
4.1.2. Microbial Growth Analysis
4.1.3. Site and Timing of Sample Collection
4.1.4. Septic Infections
4.1.5. Blood Stains
4.1.6. Material Collection Method
4.1.7. Impact on Medical Practices
4.1.8. Proposals for Further Research
4.2. Limitations
4.3. Conclusions
Implications for Practice
Author Contributions
Funding
Institutional Review Board Statement
Informed Consent Statement
Data Availability Statement
Acknowledgments
Conflicts of Interest
References
- Messina, G.; Ceriale, E.; Lenzi, D.; Burgassi, S.; Azzolini, E.; Manzi, P. Environmental Contaminants in Hospital Settings and Progress in Disinfecting Techniques. BioMed Res. Int. 2013, 2013, 429780. [Google Scholar] [CrossRef] [PubMed]
- Whittington, A.M.; Whitlow, G.; Hewson, D.; Thomas, C.; Brett, S.J. Bacterial contamination of stethoscopes on the intensive care unit. Anaesthesia 2009, 64, 620–624. [Google Scholar] [CrossRef] [PubMed]
- O’Flaherty, N.; Fenelon, L. The stethoscope and healthcare-associated infection: A snake in the grass or innocent bystander? J. Hosp. Infect. 2015, 91, 1–7. [Google Scholar] [CrossRef] [PubMed]
- Vikke, H.S.; Giebner, M. POSAiDA: Presence of Staphylococcus aureus/MRSA and Enterococcus/VRE in Danish ambulances. A cross-sectional study. BMC Res. Notes 2016, 9, 194. [Google Scholar] [CrossRef] [PubMed] [PubMed Central]
- Obenza, A.; Cruz, P.; Buttner, M.; Woodard, D. Microbial contamination on ambulance surfaces: A systematic literature review. J. Hosp. Infect. 2022, 122, 44–59. [Google Scholar] [CrossRef] [PubMed]
- Szymczyk, J.; Månsson, M.; Mędrzycka-Dąbrowska, W. Reusable tourniquets for blood sampling as a source of multi-resistant organisms- a systematic review. Front. Public Health 2023, 11, 1258692. [Google Scholar] [CrossRef] [PubMed] [PubMed Central]
- Kim, J.; Ahn, H.; Lee, E.; Chae, H. Anesthesiologist’s hand hygiene and disinfection of reusable rubber tourniquet with alcohol swabs before intravascular cannulation. Korean J. Anesthesiol. 2014, 67, S9–S10. [Google Scholar] [CrossRef]
- 2, Best Practices in Phlebotomy. In WHO Guidelines on Drawing Blood: Best Practices in Phlebotomy; World Health Organization: Geneva, Switzerland, 2010. Available online: https://www.ncbi.nlm.nih.gov/books/NBK138665/ (accessed on 12 September 2024).
- Latos, M.; Jadczak, M.; Łodzińska, M.; Szczypta, A.; Kołatek, M.; Wróblewski, Ł.; Sadownik, B.; Solecki, M.; Szymczak, A.; Pytel, M.; et al. Safe Vascular Access. Expert Recommendations of the Safe Vascular Access Working Group. 15 November 2023, Updated 31 May 2024. Available online: https://deklaracja-bezpiecznyszpital.pl/wp-content/uploads/2023/11/Raport-Recommendations-Experts-Grupa-Robocza-Bezpieczny-Dostep-Naczyniowy_WWW-1.pdf (accessed on 22 September 2024).
- Culjak, M.; Gveric Grginic, A.; Simundic, A.M. Bacterial contamination of reusable venipuncture tourniquets in tertiary-care hospital. Clin. Chem. Lab. Med. 2018, 56, e201–e203. [Google Scholar] [CrossRef]
- Parreira, P.; Serambeque, B.; Costa, P.S.; Mónico, L.S.; Oliveira, V.; Sousa, L.B.; Gama, F.; Bernardes, R.A.; Adriano, D.; Marques, I.A.; et al. Impact of an Innovative Securement Dressing and Tourniquet in Peripheral Intravenous Catheter-Related Complications and Contamination: An Interventional Study. Int. J. Environ. Res. Public Health 2019, 16, 3301. [Google Scholar] [CrossRef] [PubMed] [PubMed Central]
- Thompson, S.; Middleton, M.; Farook, M.; Cameron-Smith, A.; Bone, S.; Hassan, A. The effect of sterile versus non-sterile tourniquets on microbiological colonisation in lower limb surgery. Ann. R. Coll. Surg. Engl. 2011, 93, 589–590. [Google Scholar] [CrossRef]
- Grohmann, M.; Schomakers, L.; Wolschendorf, F.; Grosch, J.; Lindner, S.; Witte, A. Reduced bacterial contamination rates detected on silicone tourniquets compared to conventional tourniquets in clinical routine. BMC Infect. Dis. 2020, 20, 247. [Google Scholar] [CrossRef] [PubMed]
- Vandenbroucke, J.P.; von Elm, E.; Altman, D.G.; Gøtzsche, P.C.; Mulrow, C.D.; Pocock, S.J.; Poole, C.; Schlesselman, J.J.; Egger, M.; STROBE Initiative. Strengthening the Reporting of Observational Studies in Epidemiology (STROBE): Explanation and elaboration. Int. J. Surg. 2014, 12, 1500–1524. [Google Scholar] [CrossRef] [PubMed]
- Cundell, A.M. Microbial Ecology of the Human Skin. Microb. Ecol. 2018, 76, 113–120. [Google Scholar] [CrossRef] [PubMed]
- Andersen, B.M. Prevention and Control of Infections in Hospitals: Practice and Theory, 1st ed.; Springer Nature: Cham, Switzerland, 2018; pp. 337–437. [Google Scholar]
- Natarajan, A.; Das, S.; Chaudhary, N. Microbial Profile of Tourniquets Used in Phlebotomy at a Rural Tertiary Care Teaching Hospital. Cureus 2023, 15, e49328. [Google Scholar] [CrossRef] [PubMed]
- Fafliora, E.; Bampalis, V.; Lazarou, N.; Mantzouranis, G.; Anastassiou, E.; Spiliopoulou, I.; Christofidou, M. Bacterial contamination of medical devices in a Greek emergency department: Impact of physicians’ cleaning habits. Am. J. Infect. Control 2014, 42, 807–809. [Google Scholar] [CrossRef] [PubMed]
- Bielawska-Drózd, A.; Wlizło-Skowronek, B.; Cieślik, P.; Winnicka, I.; Skopińska-Różewska, E.; Kubiak, L.; Żakowska, D.; Brewczyńska, A.; Kocik, J. Evaluation of the Levels and Quality of Microbial Contamination in Medical Emergency Departments in Comparison to Other Workplaces. Pol. J. Microbiol. 2017, 65, 465–469. [Google Scholar] [CrossRef] [PubMed]
- Pitiriga, V.; Bakalis, J.; Theodoridou, K.; Kanellopoulos, P.; Saroglou, G.; Tsakris, A. Lower risk of bloodstream infections for peripherally inserted central catheters compared to central venous catheters in critically ill patients. Antimicrob. Resist. Infect. Control 2022, 11, 137. [Google Scholar] [CrossRef] [PubMed] [PubMed Central]
- Pinto, A.N.; Phan, T.; Sala, G.; Cheong, E.Y.; Siarakas, S.; Gottlieb, T. Reusable venesection tourniquets: A potential source of hospital transmission of multiresistant organisms. Med. J. Aust. 2011, 195, 276–279. [Google Scholar] [CrossRef]
- Elhassan, H.A.; Dixon, T. MRSA Contaminated Venepuncture Tourniquets in Clinical Practice. Postgrad. Med. J. 2012, 88, 194–197. [Google Scholar] [CrossRef]
- Abeywickrama, T.; Amarasinghe, K.; Wijerathne, S.; Dharmarathne, C.; Fernando, D.; Senaratne BC, V.; Gunasekara, H.A.K.M. Methicillin resistant Staphylococcus aureus contamination of phlebotomy tourniquets and faucets. Ceylon Med. J. 2018, 63, 5–10. [Google Scholar] [CrossRef] [PubMed]
- Leitch, A.; McCormick, I.; Gunn, I.; Gillespie, T. Reducing the Potential for Phlebotomy Tourniquets to Act as a Reservoir for Meticillin-Resistant Staphylococcus Aureus. J. Hosp. Infect. 2006, 63, 428–431. [Google Scholar] [CrossRef] [PubMed]
- Mehmood, Z.; Mubeen, S.M.; Afzal, M.S.; Hussain, Z. Potential Risk of Cross-Infection by Tourniquets: A Need for Effective Control Practices in Pakistan. Int. J. Prev. Med. 2014, 5, 1119–1124. [Google Scholar]
- Petersen, E.R.B.; Nybo, M. Hygiene of venepuncture tourniquets in Denmark. Scand. J. Clin. Lab. Investig. 2018, 78, 417–420. [Google Scholar] [CrossRef] [PubMed]
- Sacar, S.; Turgut, H.; Kaleli, I.; Cevahir, N.; Asan, A.; Sacar, M.; Tekin, K. Poor hospital infection control practice in hand hygiene, glove utilisation, and usage of tourniquets. Am. J. Infect. Control 2006, 34, 606–609. [Google Scholar] [CrossRef] [PubMed]
- Golder, M.; Chan, C.L.H.; O’Shea, S.; Corbett, K.; Chrystie, I.L.; French, G. Potential risk of cross-infection during peripheral-venous access by contamination of tourniquets. Lancet 2000, 355, 44. [Google Scholar] [CrossRef]

| Type of Data | CFU/cm2 Fabric | CFU Plastic | ||||||
|---|---|---|---|---|---|---|---|---|
| Length of Use | Indefinite Time | 14 Days | 28 Days | Indefinite Time | 14 Days | 28 Days | ||
| Type of Room | ||||||||
| Emergency department | pediatric room | 667 | 667 | 256 | 23 | 16 | 8 | |
| pediatric observation | 362 | 667 | 358 | 4 | 10 | 14 | ||
| adult observation | 667 | 667 | 667 | 300 | 23 | 73 | ||
| adult observation | 613 | 667 | 667 | 13 | 20 | 42 | ||
| consultation area | 9 | 327 | 667 | 2 | 3 | 16 | ||
| resuscitation area | 667 | 551 | 667 | 61 | 8 | 21 | ||
| mean: | 498 | 591 | 547 | 67 | 13 | 29 | ||
| Operating theatre | neurologic | 7 | 20 | 7 | 1 | 0 | 3 | |
| neurologic | 36 | 16 | 220 | 3 | 0 | 0 | ||
| orthopedic | 156 | 18 | 102 | 1 | 1 | 0 | ||
| orthopedic | 124 | 280 | 29 | 2 | 2 | 2 | ||
| orthopedic | 120 | 198 | 38 | 16 | 5 | 12 | ||
| gynecology | 4 | 4 | 51 | 0 | 0 | 1 | ||
| pediatric | 244 | 22 | 667 | 0 | 0 | 2 | ||
| pediatric | 13 | 13 | 213 | 0 | 0 | 18 | ||
| general surgery | 13 | 36 | 196 | 0 | 8 | 8 | ||
| general surgery | 53 | 4 | 138 | 0 | 1 | 9 | ||
| mean: | 77 | 61 | 166 | 2 | 2 | 6 | ||
| Type of Data | MacConkey CFU/cm2 | King B CFU/cm2 | ||||||
|---|---|---|---|---|---|---|---|---|
| Length of Use | Indefinite Time | 14 Days | 28 Days | Indefinite Time | 14 Days | 28 Days | ||
| Type of Room | ||||||||
| Emergency department | pediatric room | 709 | 453 | 227 | 667 | 667 | 118 | |
| pediatric observation | 191 | 911 | 487 | 667 | 667 | 231 | ||
| adult observation | 667 | 667 | 667 | 667 | 667 | 373 | ||
| adult observation | 558 | 667 | 667 | 416 | 667 | 649 | ||
| consultation area | 9 | 140 | 667 | 4 | 238 | 667 | ||
| resuscitation area | 667 | 280 | 667 | 667 | 607 | 667 | ||
| average CFU/cm2: | 467 | 520 | 564 | 515 | 586 | 451 | ||
| Operating theatre | neurologic | 0 | 27 | 0 | 11 | 22 | 0 | |
| neurologic | 13 | 4 | 0 | 33 | 11 | 427 | ||
| orthopedic | 129 | 27 | 0 | 31 | 4 | 9 | ||
| orthopedic | 144 | 187 | 0 | 44 | 236 | 0 | ||
| orthopedic | 56 | 167 | 0 | 64 | 160 | 7 | ||
| gynecology | 0 | 2 | 0 | 0 | 18 | 13 | ||
| pediatric | 33 | 24 | 0 | 131 | 18 | 667 | ||
| pediatric | 7 | 11 | 11 | 18 | 13 | 29 | ||
| general surgery | 2 | 16 | 0 | 7 | 2 | 40 | ||
| general surgery | 20 | 2 | 0 | 27 | 2 | 16 | ||
| average CFU/cm2: | 40 | 46 | 1 | 37 | 49 | 121 | ||
| Emergency Department | Operating Theatre | |||
|---|---|---|---|---|
| Fabric | Plastic | Fabric | Plastic | |
| Indefinite time | 2 of 6 tourniquets | 1 of 6 tourniquets | 3 of 10 tourniquets | 0 of 10 tourniquets |
| 14 days | 3 of 6 tourniquets | 2 of 6 tourniquets | 2 of 10 tourniquets | 2 of 10 tourniquets |
| 28 days | 2 of 6 tourniquets | 1 of 6 tourniquets | 2 of 10 tourniquets | 1 of 10 tourniquets |
Disclaimer/Publisher’s Note: The statements, opinions and data contained in all publications are solely those of the individual author(s) and contributor(s) and not of MDPI and/or the editor(s). MDPI and/or the editor(s) disclaim responsibility for any injury to people or property resulting from any ideas, methods, instructions or products referred to in the content. |
© 2025 by the authors. Licensee MDPI, Basel, Switzerland. This article is an open access article distributed under the terms and conditions of the Creative Commons Attribution (CC BY) license (https://creativecommons.org/licenses/by/4.0/).
Share and Cite
Szymczyk, J.; Kurpas, M.; Krasiński, B.; Zorena, K.; Mędrzycka-Dąbrowska, W. Reusable Tourniquets as Potential Transmitters of Infection: A Microbiological Analysis. Microorganisms 2025, 13, 152. https://doi.org/10.3390/microorganisms13010152
Szymczyk J, Kurpas M, Krasiński B, Zorena K, Mędrzycka-Dąbrowska W. Reusable Tourniquets as Potential Transmitters of Infection: A Microbiological Analysis. Microorganisms. 2025; 13(1):152. https://doi.org/10.3390/microorganisms13010152
Chicago/Turabian StyleSzymczyk, Julia, Monika Kurpas, Bartosz Krasiński, Katarzyna Zorena, and Wioletta Mędrzycka-Dąbrowska. 2025. "Reusable Tourniquets as Potential Transmitters of Infection: A Microbiological Analysis" Microorganisms 13, no. 1: 152. https://doi.org/10.3390/microorganisms13010152
APA StyleSzymczyk, J., Kurpas, M., Krasiński, B., Zorena, K., & Mędrzycka-Dąbrowska, W. (2025). Reusable Tourniquets as Potential Transmitters of Infection: A Microbiological Analysis. Microorganisms, 13(1), 152. https://doi.org/10.3390/microorganisms13010152

